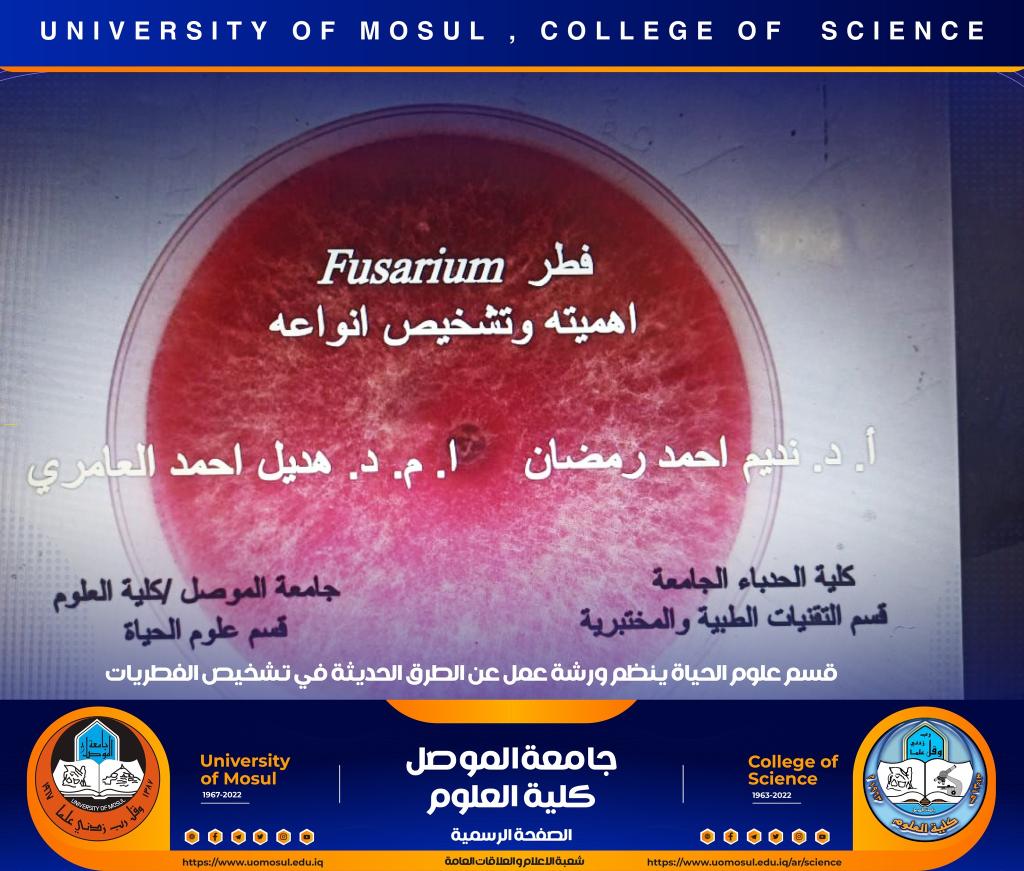
_20221224_072904_550

24 ديسمبر، 2022
ورشة عمل عن الطرق الحديثة في تشخيص الفطريات
برعاية السيد رئيس جامعة الموصل الأستاذ الدكتور قصي كمال الدين الأحمدي وبإشراف السيدة عميد كلية العلوم الأستاذ الدكتورة هيام عادل إبراهيم ، أقام قسم علوم الحياة في كليتنا ورشة عمل بعنوان ” الطرق الحديثة في تشخيص الفطريات‟ وذلك صباح يوم الأربعاء الموافق 21 كانون الأول 2022 على قاعة الدكتورة هناء الصالح في القسم حضرها عدد من التدريسين وطلبة الدراسات العليا من داخل وخارج جامعة الموصل.تضمنت الورشة أربعة محاور :اشتمل المحور الأول على التعريف بالمفاتيح التشخيصية للفطريات Aspergillus و Alternaria و Fusarium وأهمية هذه الفطريات وطرق تشخيص الأنواع التابعة لها قدّمه الأستاذ الدكتور نديم أحمد رمضان.أما المحور الثاني فتضمن أهمية الفطر Aspergillus والأمراض التي يسببها وطرق تشخيص الأنواع التابعة له مظهرياً باستخدام أوساط غذائية محددة هي وسط CYA و MEA وتشابك دوكس بدرجات حرارية مختلفة ومجهرياً بملاحظة شكل الكونيدات قدّمته الأستاذ المساعد الدكتورة فاتن نوري عبد.في حين تطرق المحور الثالث الى أهمية الفطر Alternaria والأمراض التي يسببها ودورة حياة المرض على النباتات وأهم الصفات المميزة للفطر وطرق تشخيص الأنواع التابعة له مظهرياً في الأطباق ومجهرياً عن طريق ملاحظة شكل الكونيدات وأجزاءها بمحاضرة قدّمتها الأستاذ المساعد الدكتورة ورقاء سعيد قاسم.و تطرّق المحور الرابع الى أهمية الفطر Fusarium وطرق تشخيص الأنواع التابعة له مظهرياً في الأطباق ومجهرياً بملاحظة شكل الكونيدات التي يكونها واستخدام تقنية PCR في تأكيد التشخيص المظهري والمجهري للفطر بالإضافة إلى خطوات التشخيص الجزيئي التي تتضمن تحديد الجين الهدف وتصميم البواديء وغيرها لحين الوصول إلى تحديد التتابع النيوكليوتيدي للقطع المصخمة بالاعتماد على تقنية DND sequencing ومطابقة التسلسلات الخاصة بالجينات مع تسلسلات الجينات في موقع NCBI وتحليل النتائج وتسجيل العزلات في MCBIمن خلال محاضرة قدّمتها الأستاذ المساعد الدكتورة هديل أحمد العامري.شعبة الإعلام والعلاقات العامةالسبت 24 كانون الأول 2022

























